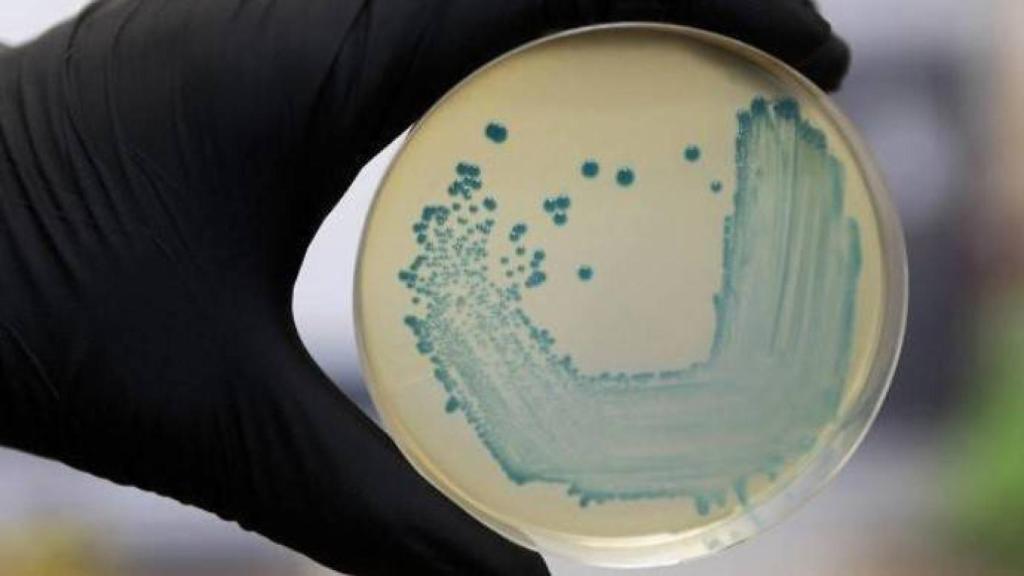
Imagen de un cultivo. Foto: EP

Imagen de un cultivo. Foto: EP
Castilla-La Mancha sigue sin infectados por listeriosis y con un caso sospechoso menos
Los posibles casos de listeriosis en Castilla-La Mancha, que han llegado a cifrarse en 11, están descendiendo día a día y descartándose el contagio en los pacientes que siguen siendo estudiados, de manera que este jueves ya solo son nueve los casos que siguen bajo sospecha.
Así lo ha dado a conocer este jueves el consejero de Sanidad del Gobierno castellano-manchego, Jesús Fernández Sanz, ha actualizado estos datos a preguntas de los medios de comunicación antes de comenzar una visita al futuro Hospital General Universitario de Toledo.
Fernández Sanz ha asegurado que Castilla-La Mancha sigue "sin ningún caso confirmado" de listerioris y que, de los casos que estaban en estudio, ya solo quedan nueve.
Por tanto, ha celebrado que no se sigan descubriendo casos nuevos de listeriosis en la región, pero sobre todo que no haya ningún caso confirmado en la comunidad autónoma, lo cual "es bueno",



